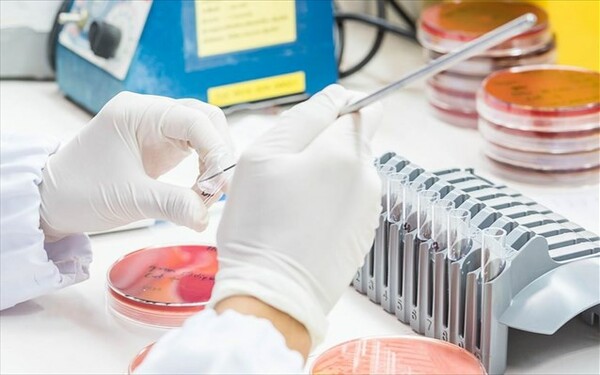

Μια αναβαθμισμένη εκδοχή του τεστ Παπανικολάου υπόσχεται τη γενετική ανίχνευση σε πρώιμο στάδιο των καρκίνων των ωοθηκών και του ενδομητρίου.
Ένας Έλληνας γιατρός της διασποράς, ο Γιώργος Παπανικολάου, δημιούργησε το διάσημο πια τεστ που φέρει το όνομά του και ένας άλλος Έλληνας, ο καθηγητής ογκολογίας και παθολογίας της Ιατρικής Σχολής του Πανεπιστημίου Τζονς Χόπκινς Νικόλας Παπαδόπουλος, έρχεται σήμερα να το «αναβαθμίσει», μαζί με συναδέλφους του στις ΗΠΑ, έτσι ώστε να επιτυγχάνει την πρώιμη διάγνωση του καρκίνου των ωοθηκών και του ενδομητρίου στις γυναίκες.
Εδώ και χρόνια το τεστ Παπ έχει βοηθήσει σημαντικά σε όλο τον κόσμο να μειωθούν τα περιστατικά καρκίνου του τραχήλου της μήτρας.
Τώρα φαίνεται πως, στην αναβαθμισμένη του μορφή, με την ονομασία PapSEEK, το νέο τεστ μπορεί να αποτελέσει μελλοντικά μια ασφαλή και ελάχιστα επεμβατική τεχνική για την πιο έγκαιρη διάγνωση δύο άλλων συχνών μορφών καρκίνου, του ενδομητρίου και των ωοθηκών.
Πρόκειται για διαδεδομένους γυναικολογικούς καρκίνους, που συχνά είναι δύσκολο να θεραπευθούν, επειδή μπορεί να εξαπλωθούν σε άλλα σημεία του σώματος, προτού εκδηλωθούν τα πρώτα συμπτώματα.
Τα υπάρχοντα τεστ είναι επεμβατικά και παρέχουν πολλά ψευδώς θετικά αποτελέσματα (δηλαδή «βρίσκουν» καρκίνους που στην πραγματικότητα δεν υπάρχουν).
Το νέο τεστ αφήνει υποσχέσεις ότι θα μπορεί να τους «πιάνει» σε ένα πιο πρώιμο και άρα θεραπεύσιμο στάδιο, πιθανώς ήδη από το προκαρκινικό στάδιο.
Οι ερευνητές, με επικεφαλής τον δρα Ν. Παπαδόπουλο, που έκαναν τη σχετική δημοσίευση στο αμερικανικό ιατρικό περιοδικό «Science Translational Medicine», εκμεταλλεύθηκαν το γεγονός ότι τα καρκινικά κύτταρα από τους δύο αυτούς καρκίνους συχνά μεταφέρονται στο κολπικό κανάλι, όπου είναι δυνατό να συλλεχθούν από το τεστ Παπ.
Στη συνέχεια, το τεστ PapSEEK αναλύει το DNA των δειγμάτων που έχουν συλλεχθεί από το αρχικό τεστ Παπ και μπορεί να ανιχνεύσει τις πιο κοινές γενετικές μεταλλάξεις (συνολικά 18 γονίδια), που έχουν βρεθεί ότι σχετίζονται με τους δύο γυναικολογικούς καρκίνους.
Οι επιστήμονες δοκίμασαν την αποτελεσματικότητα του νέου τεστ σε δείγματα Παπ από 382 ασθενείς με καρκίνο του ενδομητρίου, 245 με καρκίνο των ωοθηκών και 714 υγιείς.
Το PapSEEK ανίχνευσε το 81% των καρκίνων του ενδομητρίου και το 33% των καρκίνων των ωοθηκών.
Τα ποσοστά αυξήθηκαν σε 93% και 45% αντίστοιχα, όταν τα δείγματα του τεστ Παπ συλλέχθηκαν με ένα διαφορετικό εργαλείο (Tao), που επιτρέπει να γίνεται λήψη ιστού πιο κοντά στην περιοχή των όγκων.
Στη συνέχεια, η μέθοδος βελτιώθηκε περαιτέρω και το ποσοστό διάγνωσης των καρκίνων των ωοθηκών αυξήθηκε στο 63%, όταν το PapSEEK συνδυάσθηκε με την ανίχνευση του DNA του όγκου στο αίμα της ασθενούς.
Ήδη, οι ερευνητές έχουν ξεκινήσει να κάνουν μια μεγαλύτερη κλινική δοκιμή. Ελπίζουν ότι σε δύο έως τρία χρόνια το νέο τεστ θα μπορεί να αξιοποιηθεί κλινικά, αν και δεν αποκλείουν να χρειασθεί ακόμη μεγαλύτερο χρονικό διάστημα.
Στις αρχές του έτους, ο Ν. Παπαδόπουλος είχε δημιουργήσει διεθνή θόρυβο, όταν ως επικεφαλής μιας αμερικανικής επιστημονικής ομάδας είχε ανακοινώσει στο περιοδικό «Science» ένα σημαντικό βήμα για την ανάπτυξη ενός καθολικού τεστ αίματος που θα μπορεί να διαγνώσει ταυτόχρονα οκτώ διαφορετικά είδη καρκίνου.
Πρόκειται για το μη επεμβατικό τεστ υγρής βιοψίας με την ονομασία CancerSEEK, το οποίο αναλύει το DNA που κυκλοφορεί στο αίμα και ελέγχει την παρουσία μεταλλάξεων σε 16 γονίδια και οκτώ πρωτεΐνες, που συνδέονται με τον καρκίνο.
Το τεστ δεν είναι ακόμη έτοιμο για κλινική χρήση και ήδη δοκιμάζεται σε περισσότερους ασθενείς.
Ο δρ Νικόλας Παπαδόπουλος αποφοίτησε από το Αριστοτέλειο Πανεπιστήμιο Θεσσαλονίκης (1985), το 1992 πήρε το διδακτορικό του από την Ιατρική Σχολή του Πανεπιστημίου του Τέξας στο Χιούστον και ολοκλήρωσε την ιατρική εκπαίδευση του στο πεδίο της ογκολογίας στο Πανεπιστήμιο Τζονς Χόπκινς της Βαλτιμόρης.

σχόλια